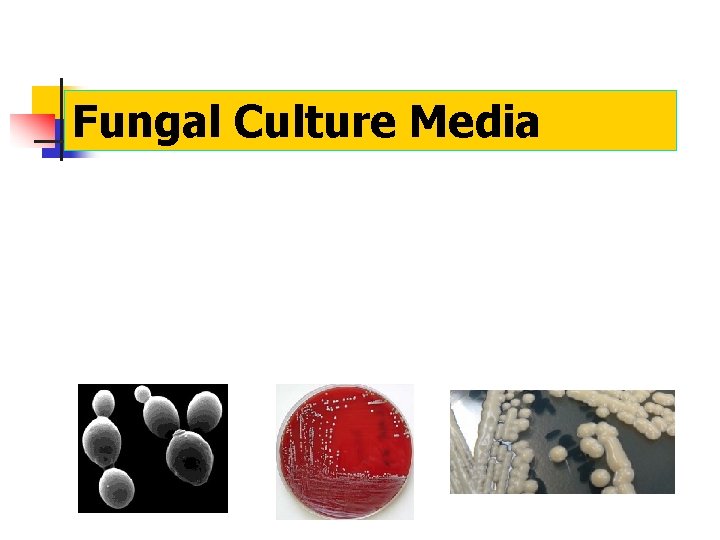
Fungal Culture Media
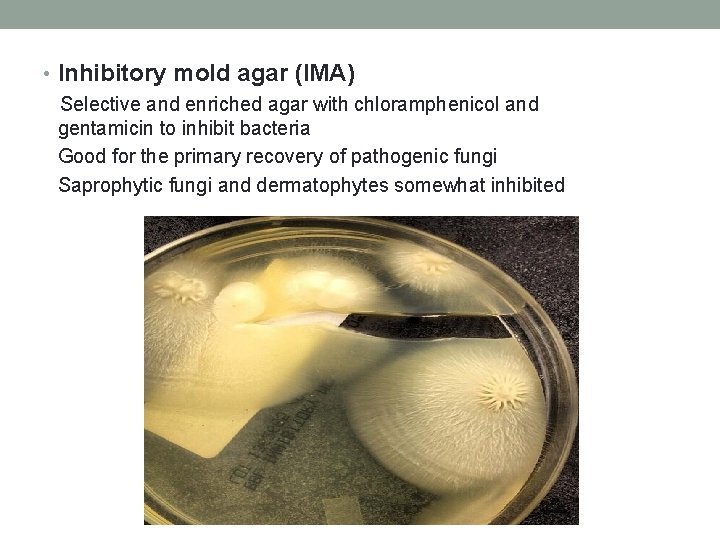
• Inhibitory mold agar (IMA) Selective and enriched agar with chloramphenicol and gentamicin

Fungal Culture Media Fungal Culture n Tubed media
Fungal Culture Media

Fungal Culture n Tubed media is used rather than plated media. n n Less chance for spore release into the environment. Less chance for dehydration. Easier storage. The agar in a tube is inoculated in a straight line. Preliminary identification is based on differential growth patterns on various media.

Fungal Culture Media • Sabouraud’s glucose agar (SABS) All purpose Fungal media – No antibiotics Best used for subculture of fungi for identification workup Ingredients Gm/L Mycological peptone (enzymatic digest of casein and animal tissues) 10 gm Dextrose 40 gm Agar 15 gm n n Sabouraud's dextrose agar classic medium, recommended for most studies. Sabouraud's dextrose agar with chloramphenicol (inhibits bacterial growth) p. H 5. 6 at 250 C

Sabouraud Dextrose Agar, Emmons Modification Agar Medium Sabouraud Agar Modified (BD 274720)…………. . 50. 0 g DI Water………………………. . . 1000 ml Autoclave at 121º C. Broth Medium Sabouraud Broth (BD cat 238230)………………. . 30. 0 g DI Water…………………. ……. …. 1000 ml Autoclave at 121º C. *This product is commercially available from BD. To make medium from scratch, follow formulation below: Sabouraud Dextrose Agar, Emmons Modification Composition Neopeptone………………. . ………… 10. 0 g Dextrose……………. . ………. 20. 0 g Agar…………………. . . 20. 0 g DI Water…………. . . . . ………… 1000 ml Final p. H 7. 0 +/- 0. 2. Omit agar for broth medium. *This medium is a modification of regular Sabouraud Dextrose Agar. It contains a reduced amount of dextrose and has a neutral p. H.

What effect does Cycloheximide have when added to media? • Prevents rapidly growing environmental molds from overgrowing pathogenic fungal species • This is the good aspect of cycloheximide in media • Beware: it is not all good, it can suppress important fungi from growing. Inhibited fungi include: • Trichosporon beigelii • Candida tropicalis • Cryptococcus neoformans • Yeast phase of Blastomyces • Yeast phase of Histoplasma

Sabouraud’s Dextrose Agar (SDA) Creamish in color, translucent ( c/w LSS)

LSS Milky white, opaque
• Inhibitory mold agar (IMA) Selective and enriched agar with chloramphenicol and gentamicin to inhibit bacteria Good for the primary recovery of pathogenic fungi Saprophytic fungi and dermatophytes somewhat inhibited

Fungal Culture Media • Mycosel/Mycobiotic agar • Selective SABS agar with chloramphenicol and cycloheximide • Used for selective culture of dermatophytes – fungi that cause skin, hair and nail infections

• Brain heart infusion agar • Primary recovery of all fungi • Can inhibit bacterial growth by adding chloramphenicol and cycloheximide • Can add blood to agar to nurture systemic fungi • Fungal cultures are incubated for 4 weeks at 30˚C • Lower temperature than bacterial culture incubation [35˚C] • If agar plates are used for fungal cultures the plates must be sealed with air permeable tape to prevent spore dissemination from plates

Slide Culture • in order to accurately identify many fungi it is essential to observe the precise arrangement of the conidiophores and the way in which spores are produced


Processing of Fungal Cultures • Inoculate fungal media with specimen • Seal plates with tape to prevent culture contamination and escape of fungal spores • Incubate at 30˚C for 4 wk • If growth occurs - perform proper identification methods: Yeast identification methods Manual and automated biochemical reactions capable of identifying most but not all yeast species. Newer methods (1) Mass spectrometry – MALDI-TOF and (2) 16 s. RNA sequencing are more precise methods with the expanding taxonomy of yeast species.

Safety in the Mycology Laboratory • If a culture is growing a mold, it cannot be opened on the bench top • All mold work must be performed in a BSL-2 biosafety cabinet with Hepa filtration • Yeast identification can be performed on the bench top

Direct Exams used to identify fungi directly from patient specimens • Gram stain – Most specimen types can be Gram stained. Reliable detection of yeast • KOH preparation – Skin, Hair or Nails examined for both yeast and/or hyphae • Calcofluor white stain – Most specimen types can be stained and examined for yeast and/or hyphae • India ink – Primarily used on CSF for the detection of Cryptococcus neoformans and C. gattii
![Gram Stain • Yeast cells stain blue [Gram positive]. • Examine stain for budding Gram Stain • Yeast cells stain blue [Gram positive]. • Examine stain for budding](http://slidetodoc.com/presentation_image_h2/23fa9a6efcf50343cf355cce6bd5c8a6/image-16.jpg)
Gram Stain • Yeast cells stain blue [Gram positive]. • Examine stain for budding cells to confirm that it is a yeast cell and not an artifact. • You can also detect pseudo-hyphae on Gram stain. • Mold can be difficult to detect on a Gram stain. pseudohyphae mold pseudohyphae X 100 oil immersion

KOH – potassium hydroxide prep • Detect yeast and/or pseudo-hyphae in skin, hair and nail specimens using 40 X light microscopy. • KOH dissolves keratin found in cellular material and freeing fungal hyphae and yeast cells. • KOH exams can be difficult to interpret!

Calcofluor white stain • Yeast, pseudo-hyphae, and mycelial fungi will bind with the Calcofluor white stain and fluoresce. • Read using a fluorescence microscope (40 X) • More Sensitive and Specific than KOH preparation.

India Ink One drop of black ink is placed into one drop of CSF On microscope slide - examined using light microscope (40 X) It is a “negative” stain – which stains the background not the yeast cell. The clearing around the yeast is due to the polysaccharide capsule of Cryptococcus neoformans and C. gattii.
![Examination of fungi in fixed tissue Grocott’s Methenamine Silver Stain [GMS] – yeast and Examination of fungi in fixed tissue Grocott’s Methenamine Silver Stain [GMS] – yeast and](http://slidetodoc.com/presentation_image_h2/23fa9a6efcf50343cf355cce6bd5c8a6/image-20.jpg)
Examination of fungi in fixed tissue Grocott’s Methenamine Silver Stain [GMS] – yeast and hyphae stain grey to black. Will stain living and dead fungi • Observe the width of the hyphae, presence of septations and angle of branching. • Observe the size and budding pattern of yeast. • Observe on later slides how these oservations can assist in identification.
![Periodic Acid Schiff [PAS] Positive staining hyphae will appear magenta – will also stain Periodic Acid Schiff [PAS] Positive staining hyphae will appear magenta – will also stain](http://slidetodoc.com/presentation_image_h2/23fa9a6efcf50343cf355cce6bd5c8a6/image-21.jpg)
Periodic Acid Schiff [PAS] Positive staining hyphae will appear magenta – will also stain structures containing a high proportion of carbohydrate macromolecules (glycogen, glycoprotein, proteoglycans) Stains living fungi.
![Mucicarmine [Mucin] stain Mucicarmine stains the polysaccharide capsule pink for Cryptococcus neoformans and C. Mucicarmine [Mucin] stain Mucicarmine stains the polysaccharide capsule pink for Cryptococcus neoformans and C.](http://slidetodoc.com/presentation_image_h2/23fa9a6efcf50343cf355cce6bd5c8a6/image-22.jpg)
Mucicarmine [Mucin] stain Mucicarmine stains the polysaccharide capsule pink for Cryptococcus neoformans and C. gatti. Also stains mucin in fixed tissue.

Hematoxylin and Eosin Stain Great for cellularity, not a specific stain for fungi.

End of Lecture
- Slides: 24